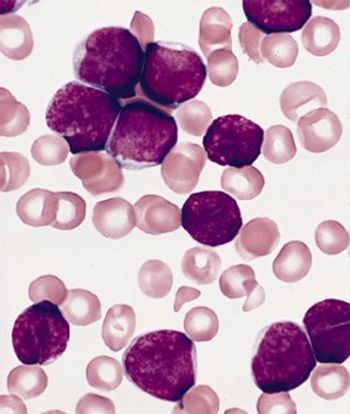

In this video from the 2014 ASH Meeting, Dr. Grupp discusses data from a trial using CAR T-cell therapy in children and young adults with relapsed, treatment-resistant ALL.

Your AI-Trained Oncology Knowledge Connection!


In this video from the 2014 ASH Meeting, Dr. Grupp discusses data from a trial using CAR T-cell therapy in children and young adults with relapsed, treatment-resistant ALL.

T-lymphoblastic leukemia (T-ALL) should no longer be considered a poor-risk disease in the pediatric population, according to data presented at ASH.

Monitoring minimal residual disease and real-time quantitative polymerase chain reaction can predict relapse in pediatric acute lymphoblastic leukemia patients.

Results of a new study show that cancer rates among children and adolescents are stable, but rates of certain cancers such as renal carcinomas are increasing.

Long-term outcomes of patients treated for pediatric acute lymphoblastic leukemia (ALL) with modern treatment protocols are good, with an overall low risk for serious long-term side effects.

Researchers have identified Down syndrome as a risk factor for infection-related mortality among pediatric patients with acute lymphoblastic leukemia.

A new risk-stratification system for pediatric and young adult patients with non-rhabdomyosarcoma soft-tissue sarcomas (NRSTS) was able to effectively classify patients for the appropriate therapy.

High-dose chemotherapy plus conventional radiotherapy resulted in a high 3-year overall survival in children and adolescents with newly diagnosed medulloblastoma and supratentorial primitive neuroectodermal tumor.

Obesity or underweight status at diagnosis can influence outcomes in pediatric ALL patients, but a new study shows that the risk can be mitigated if weight status changes following treatment induction.

Contrary to some previous research as well as popular belief, living underneath or near to power lines as a child may not have any notable effect on childhood leukemia risk, according to a new case-control study conducted in the United Kingdom.

Treatment with gemtuzumab ozogamicin improved the event-free survival in children and adolescents with acute myeloid leukemia by reducing the risk of relapse among those able to achieve remission, according to trial results presented at the 2013 ASH meeting.
Adult survivors of pediatric acute lymphoblastic leukemia (ALL) suffer from persistent and significant neurocognitive deficits, according to a new study.

A mutation of the PAX5 gene has been found to play an important role in inherited cases of B-cell precursor acute lymphoblastic leukemia (B-ALL). The mutation was isolated in two unrelated families with high propensity for B-ALL.

A phase I study of dasatinib in children and adolescents with chronic myeloid leukemia (CML) and other malignancies determined dosing for further studies and suggested the drug is well tolerated and effective in these patients.

The multikinase angiogenesis inhibitor pazopanib was well tolerated and exhibited some responses in pediatric patients with soft-tissue sarcomas and other refractory solid tumors in a phase I trial.

Use of the bisphosphonate pamidronate (Aredia) may be “more efficient” than standard regimens as palliative treatment for symptoms of acute symptomatic osteonecrosis in pediatric patients with acute lymphoblastic leukemia.

Combination chemotherapy with sequential administration of methotrexate and asparaginase was found to be effective salvage therapy in a small retrospective study of pediatric patients with relapsed or refractory acute myeloid leukemia (AML).

The US Food and Drug Administration has approved imatinib (Gleevec) for the treatment of newly diagnosed Philadelphia chromosome–positive acute lymphoblastic leukemia (Ph+ ALL) in children.

Future studies of adult medulloblastoma should include whole genome sequencing and identification of the tumorigenic cell origin of adult medulloblastoma. Ultimately, quality prospective trials are needed in adult medulloblastoma patients in order to optimize the management of this rare and complex disease.

When facing decisions involving children with cancer at the end of life, three themes drove parental decision making--communication, extending time, and understanding prognosis, according to a recent meta-analysis.

The FDA approved a dissolvable form of everolimus (Afinitor Disperz) for the treatment of children with subependymal giant cell astrocytoma (SEGA) that cannot be treated with surgery.

In a phase I study the targeted drug crizotinib, a small molecule inhibitor of anaplastic lymphoma kinase and met proto oncogene, delayed or eliminated signs of tumor growth in pediatric patients with aggressive cancers.

Children diagnosed with non-central nervous system cancers at a very young age tend to reach some neurodevelopmental milestones later than healthy children, according to a new study.

The article by Dr. George is of great use to the practicing clinician, not only in the hematology-oncology setting but also in general practice or emergency medicine.

The cure of childhood acute lymphocytic leukemia (ALL) stands at the top of medicine's achievements in the struggle against cancer.